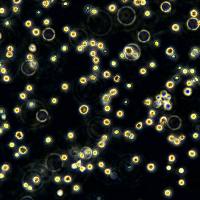
浙江美森-小鼠肝癌细胞 H22

相关产品推荐更多 >
万千商家帮你免费找货
0 人在求购买到急需产品
- 详细信息
- 技术资料
- 英文名:
UPCISCC090
- 规格:
T25/冻存管
| 规格 | T25 |
| 货号 | CTCC-007-0185 |
| 种属 | 人源(Homo sapiens) |
| 组织来源 | 舌(Tongue) |
| 疾病 | 鳞状细胞癌(Squamous cell carcinoma) |
| 年龄 | 46岁(46 years) |
| 培养体系 | 该细胞系培养所用基本培养基为 Dulbecco’s Modified Eagle’s Medium (DMEM), 配置完全培养基时需加入 10%FBS,1% Anti-Anti。 |
| 细胞形态 | 表皮细胞(Epithelial) |
| 生长特性 | 贴壁生长(Adherent) |
UPCI:SCC090是一种人舌鳞状细胞癌(OSCC)细胞系,源自一位口腔舌鳞癌患者的原发性肿瘤组织。该细胞系是头颈部鳞状细胞癌(HNSCC)研究领域的重要工具,特别专注于研究舌癌这一特定原发部位的生物学行为。
其在分子层面上通常携带头颈部鳞癌常见的遗传改变,例如TP53肿瘤抑制基因的突变。值得注意的是,它与高危型人乳头瘤病毒(HPV)感染无关,属于HPV阴性口腔癌模型,这使其在研究HPV阴性(通常与烟草、酒精等危险因素相关)舌癌的发病机制中具有特定价值。
因此,UPCI:SCC090被广泛应用于探究舌鳞癌的细胞增殖、侵袭、转移、上皮-间质转化(EMT)等恶性行为及其背后的分子机制。该细胞系是筛选和评估针对舌癌或头颈部鳞癌的化疗药物(如顺铂)、靶向疗法及放射治疗效果的重要临床前模型,为改进这一常见口腔恶性肿瘤的治疗策略提供了实用的研究平台。


风险提示:丁香通仅作为第三方平台,为商家信息发布提供平台空间。用户咨询产品时请注意保护个人信息及财产安全,合理判断,谨慎选购商品,商家和用户对交易行为负责。对于医疗器械类产品,请先查证核实企业经营资质和医疗器械产品注册证情况。
技术资料暂无技术资料 索取技术资料
浙江美森-舌头鳞癌细胞 UPCISCC090
¥3500